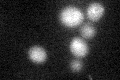
YOR097C

View description
Putative protein of unknown function; identified as interacting with Hsp82p in a high-throughput two-hybrid screen; YOR097C is not an essential gene
Localization:
Intensity:
Fold change:
Significance:
-
C’ GFP library in SD

below threshold16.05 -
N' NOP1pr-GFP in SD

N/A0 -
N' TEF2pr-mCherry in SD

N/A0 -
N' NATIVEpr-GFP in SD

N/A0 -
N' TEF2pr-VC and Cyto-VN in SD

N/A0 -
C’ GFP library in SD+DTT
cytosol17.391.08No -
C’ GFP library in SD+H2O2

cytosol18.321.14No -
C’ GFP library in Starvation Media

cytosol18.061.12No -
C’ GFP library on the background of Pup2-DaMP

below threshold -
C’ GFP library on the background of CCT mutant

below threshold16.70771.04065No
